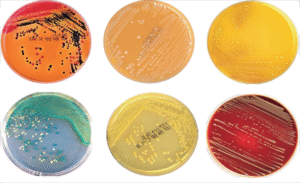

Lưu trữ danh mục: Bài viết
Vi khuẩn cố định nitơ cộng sinh với cây bộ đậu
Đặc điểm chung Vi khuẩn cố dịnh nitơ cộng sinh với cây bộ đậu còn...
Chủ trang trại lợn bỏ nghề tiết lộ điều khủng khiếp về chất cấm
Đơn cử như thịt heo, ai đã chỉ cho ai mà một nông dân ở...
Vai trò của cỏ dại
Mỗi lá cây đầy diệp lục sẽ là những tấm pin năng lượng mặt trời...
Cách ủ phân bò bằng chế phẩm EM
Công thức ủ cho 10 tấn phân bò Chuẩn bị: Đào hố sâu khoảng 0.5...
Quá trình sinh hoá trong việc ứng dụng visinh (EM) vào xử lý hầm biogas
Quá trình các phản ứng vi sinh hóa xảy ra trong quá trình sản xuất...
Hướng dẫn chung cách ủ phân chuồng, vỏ bã phụ phẩm nông nghiệp
Bước 1: ủ chay với nước: Nguyên liệu là phân chuồng các loại, vỏ bã...
Công dụng của tỏi trong nuôi trồng thủy sản
Tỏi được dùng để phòng trị nhiều bệnh (đường ruột, phân trắng, đốm trắng, gan...
Một số loài vi khuẩn trong đất có thể phân hủy và sử dụng kháng sinh làm thức ăn
Tiếp xúc với kháng sinh từ các hoạt động sản xuất nông nghiệp như chăn...
Phân loại và danh pháp vi sinh vật
1. SỰ PHÂN CHIA SINH GIỚI Năm 1753, Linnaeus lần đầu tiên xếp các sinh...
Chế phẩm sinh học có hiệu quả trong việc chống lại vi khuẩn gây bệnh hoại tử gan tụy cấp EMS/AHPND trên tôm thẻ chân trắng
Bệnh EMS/AHPND là một bệnh có liên quan đến các vấn đề về quản lý...